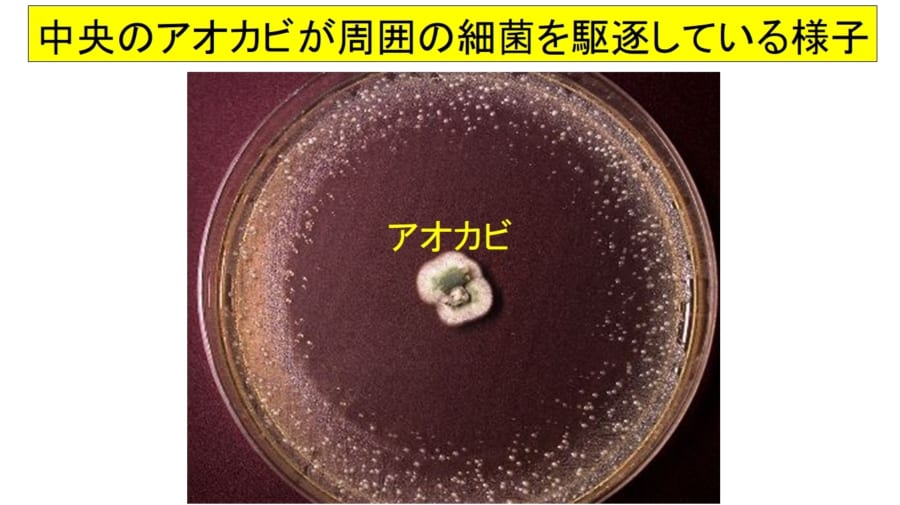
Fleming, Alexanderアレクサンダー・フレミングの展示中Museum of THOMAS16031 - ミューゼオ -Muuseo

アレクサンダー フレミング ペニシリン (331 無料画像)
218 アレクサンダー フレミング Stock Photos, High-Res Pictures, and Images - Getty Images。
アレクサンダー・フレミング - Onlineジャーニ。
Sputnik 日本 on X: "🗓️1928年9月28日、英国の細菌学者アレクサンダー・フレミング が培養中のシャーレで青カビが細菌を殺す現象を発見。後に世界初の抗生物質「ペニシリン」として実用化され、感染症治療の発展のきっかけとなった。今日は何の日_Sputnik https:t.co。
小さなカビの区画が170万円で売れるざっくり英語ニュース! WEBアーカイブ。
アレキサンダー・フレミングとリゾチーム岡崎 好秀 先生モリタメールマガジン スマイル+ Plus歯科情報ポータルサイトデンタルプラザ。
アレクサンダー・フレミング 01809012126 の写真・イラスト素材アマナイメージズ。
アレクサンダー・フレミング – イラストストック「時短だ」。
ペニシリン penicillinChem-Stationケムステ。
今日、ノーベル賞を受賞したダーベル出身のアレクサンダー・フレミング、ペニシリンを発見した人を記念して、ダーベルで壁画が完成しました。 :r Scotland。
生理学・医学賞 まんがで振り返るノーベル賞!ガッコミ。
紙幣 スコットランド Clydesdale Bank 5 pound ペニシリンの発見者アレクサンダー・フレミング 2009年。
世界初の抗生物質「ペニシリン」の元になったアオカビのDNA配列がやっと解読される!発見当時から"遺伝子が変異していた"という驚きの結果 - ナゾロジ。
2025年 アレクサンダー フレミング研究室博物館 - 出発前に知っておくべきことすべて - トリップアドバイザ。
penicillin in DD-peptidase1.jpg。
アレクサンダー・フレミング - Onlineジャーニ。
世界の歴史 > 1920年代の出来事 > フレミングがペニシリンを発明 1928年9月TV・出版・報道向け写真ならアフロ。
Fleming, Alexanderアレクサンダー・フレミングの展示中Museum of THOMAS16031 - ミューゼオ -Muuseo。
偉人の紹介① ~アレクサンダー・フレミング~ルーラー0410。
ゆっくり解説 ゆっくり医学史魔法の弾丸「ペニシリン」発見の歴史。
ペニシリンの発見者、サー・アレクサンダー・フレミング1881-1955。
11件の「アレクサンダー フレミング」のベクター画像素材、ベクター素材Shutterstock。
ペニシリンの発見者であるアレクサンダーフレミングの図解された肖像画。高品質のイラストの写真素材・画像素材 Image 193839937。
世界の歴史 > 1920年代の出来事 > フレミングがペニシリンを発明 1928年9月TV・出版・報道向け写真ならアフロ。
Vol.03アレクサンダー・フレミング細菌学者sciencingstyle。
今日、ノーベル賞を受賞したダーベル出身のアレクサンダー・フレミング、ペニシリンを発見した人を記念して、ダーベルで壁画が完成しました。 :r Scotland。
世界初の抗生物質「ペニシリン」の元になったアオカビのDNA配列がやっと解読される!発見当時から"遺伝子が変異していた"という驚きの結果 - ナゾロジ。
Amazon.co.jp: Mould Juice ペニシリン アレクサンダー・フレミング 分子式 構造式 化学式 1928 医療 抗生物質 英語ジップパーカー : ファッション。
芍薬 アレキサンダーフレミング 世界初の抗生物質ペニシリンの発見者の方のお名前。
ペニシリンの発見者であるアレクサンダーフレミングの図解された肖像画。高品質のイラストの写真素材・画像素材 Image 193839935。
日本製薬工業協会JPMAon X: "今日はペニシリンの日 1928年にアレクサンダーフレミングは、細菌の研究から「奇跡のくすり」と呼ばれたペニシリン を発見👀その後、別の研究者の手で、治療薬として開発・大量生産され、細菌を原因とする病気の治療に役立ってい。
世界の歴史 > 1920年代の出来事 > フレミングがペニシリンを発明 1928年9月TV・出版・報道向け写真ならアフロ。
AmazonMould Juice ペニシリン アレクサンダー・フレミング 分子式 構造式 化学式 1928 医療 抗生物質 英語 TシャツTシャツ・カットソー 通販。
2 12ペニシリンの日です。今日と明日12 水 、13 木 は瓢 ひさご お休みですm _ _ m地魚食道 瓢のニュースまいぷれ 新潟市。